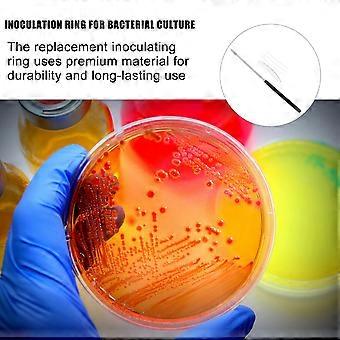
product image
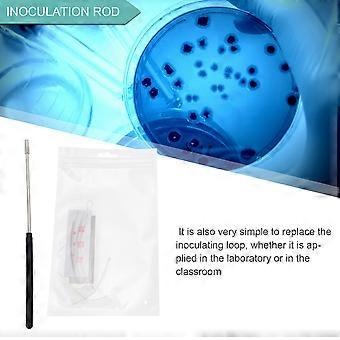
product image
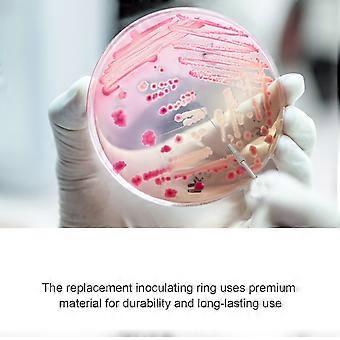
product image

1 Set Biological Experiment Inoculation Rod Laboratory Tool for Bacterial
والشحن مجاناً
1 Set Biological Experiment Inoculation Rod Laboratory Tool for Bacterial
- العلامة التجارية: Unbranded

1 Set Biological Experiment Inoculation Rod Laboratory Tool for Bacterial
- العلامة التجارية: Unbranded
| سعر البيع القطاعي المقترح: | |
| السعر: | |
| أنت توفر: | ١١١٫٠٥ ر.ق. (74%) |
في المخزون
سياسة الإرجاع لمدة 14 يوما
نقبل وسائل الدفع الآتية
الوصف
1 Set Biological Experiment Inoculation Rod Laboratory Tool for Bacterial
- العلامة التجارية: Unbranded
- الفئة: مجموعات ألعاب العلوم و الاكتشافات
- هوية Fruugo: 264612548-583107378
- EAN: 4922385171242
معلومات سلامة المنتج
يرجى الاطلاع على معلومات سلامة المنتج الخاصة بهذا المنتج الموضحة أدناه
يتم توفير المعلومات التالية من قبل بائع التجزئة المستقل التابع لجهة خارجية الذي يبيع هذا المنتج.
ملصقات سلامة المنتج

التسليم والرد
يُرسل خلال 24 ساعة
-
STANDARD: مجاناً - التسليم بين الجمعة 26 ديسمبر 2025 – الجمعة 02 يناير 2026 - مجاناً
يُشحن من الصين.
نحن نبذل قصارى جهدنا لضمان أن تصلك المنتجات التي تطلبها بالكامل وطبقاً المواصفات التي حددتها. إلا أنه في حال تلقيك طلب غير كامل أو أغراض تختلف عن تلك التي طلبتها أو كان هناك سبب آخر يدعوك لعدم الرضاء عن الطلب، فيمكنك رد الطلب أو أي منتجات يتضمنها الطلب واسترداد ما دفعته من أجل تلك الأغراض بالكامل. عرض سياسة الرد الكاملة
تفاصيل امتثال المنت
يرجى الاطلاع على معلومات الامتثال الخاصة بهذا المنتج الموضحة أدناه.
يتم توفير المعلومات التالية من قبل بائع التجزئة المستقل التابع لجهة خارجية الذي يبيع هذا المنتج.
الجهة المصنعة:
توضح المعلومات التالية تفاصيل الاتصال الخاصة بالجهة المصنعة للمنتج ذي الصلة والذي يُباع على Fruugo.
- Shenzhen Huiwenzhong Technology Co., Ltd.
- Shenzhen Huiwenzhong Technology Co., Ltd.
- C205-R, Building C, No. 19 Yinzhu Road, Nanlian Community, Longgang Street, Longgang District, Shenzhen City
- Shenzhen
- CN
- 518000
- upleture@hotmail.com
- 19928320113
الشخص المسؤول في الاتحاد الأوروبي:
توضح المعلومات التالية معلومات الاتصال الخاصة بالشخص المسؤول في الاتحاد الأوروبي. الشخص المسؤول هو المُشغل الاقتصادي المُعيّن والكائن في الاتحاد الأوروبي والمسؤول عن التزامات الامتثال المتعلقة بالمنتج ذي الصلة الذي يُباع داخل الاتحاد الأوروبي.
- EC REP SERVICES SL
- EC REP SERVICES SL
- Calle Gran Via 49, 7 Dch.
- Madrid
- ES
- 28013
- ecrepservice@hotmail.com
- 0034 910 5631 02